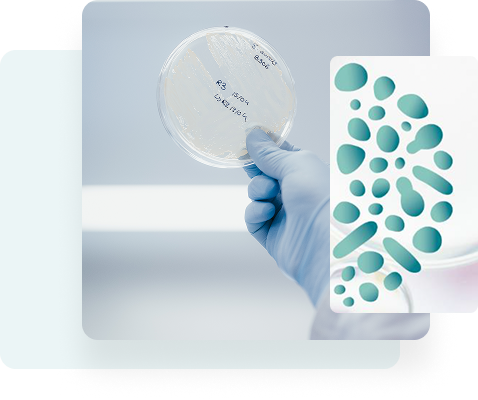
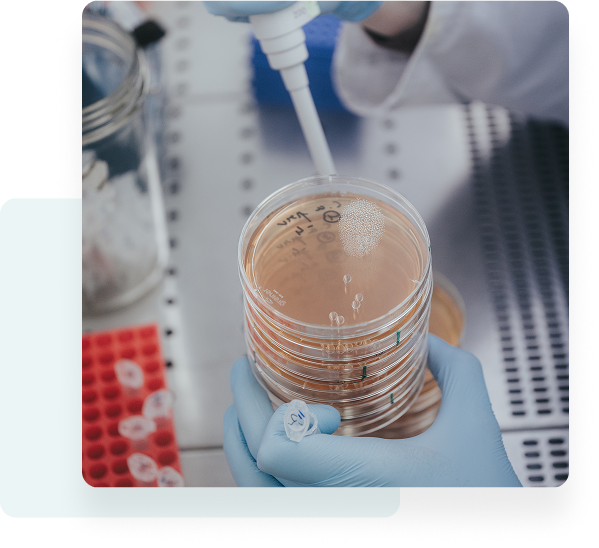

Comprenez l’impact de vos soins sur l’écosystème microbien du cuir chevelu pour des produits plus performants et mieux tolérés.
Le cuir chevelu abrite une flore microbienne spécifique jouant un rôle central dans l’équilibre cutané et capillaire. Déséquilibres, pellicules, dermatite séborrhéique, démangeaisons, excès de sébum… de nombreux troubles sont liés à une perturbation de cet écosystème. BYOME LABS propose des analyses ciblées pour étudier l’impact de vos shampooings, sérums ou lotions sur le microbiome du cuir chevelu.

Une approche scientifique au service de l’innovation cosmétique
Sandra, DEMAIN BEAUTY
Sandra, DEMAIN BEAUTY
Sandra, DEMAIN BEAUTY
Prouvez leur innocuité et leur respect du microbiome du cuir chevelu
Vos questions sur le microbiome capillaire
Vous désirez prendre rendez-vous ou souhaitez plus d’informations ?
Vous pouvez nous joindre en remplissant le formulaire de contact ci-contre ou par mail à : info@byome-labs.v-labs.fr
BYOME LABS
Cité de l’Innovation
7 rue Auguste Rodin
28630 LE COUDRAY
This site is protected by reCAPTCHA and the Google Privacy Policy and Terms of Service apply.
Votre cuir chevelu héberge des milliards de micro-organismes formant le microbiome du cuir chevelu. Cet écosystème complexe, constitué d’un équilibre délicat entre bactéries, champignons et autres micro-organismes, détermine la santé de vos cheveux et protège contre les pellicules, démangeaisons et autres désordres capillaires.
Le microbiome du cuir chevelu représente l’ensemble des micro-organismes vivant à la surface de votre cuir chevelu. Cette communauté microbienne unique interagit avec la production de sébum, maintient l’équilibre du pH et forme une barrière protectrice contre les agents pathogènes comme les pellicules ou la dermatite séborrhéique.(1–3)
Trois grandes familles de micro-organismes dominent le microbiome du cuir chevelu (1) :
Cette composition varie selon les zones du cuir chevelu, l’âge et les caractéristiques individuelles, créant un écosystème unique pour chaque personne.
Le microbiome du cuir chevelu remplit plusieurs rôles fondamentaux pour la santé capillaire :
Protection antimicrobienne : Les micro-organismes bénéfiques produisent des peptides antimicrobiens qui limitent la prolifération des pathogènes (3). Cette défense naturelle prévient les infections et maintient l’équilibre de l’écosystème.
Régulation sébacée : Cutibacterium acnes métabolise les lipides et influence directement la production de sébum. Cette régulation maintient l’hydratation optimale du cuir chevelu (4).
Maintien de la barrière cutanée : L’équilibre entre populations bactériennes et fongiques préserve l’intégrité de la barrière cutanée, limitant inflammations et irritations (2).
De nombreux éléments du quotidien peuvent déséquilibrer le microbiome du cuir chevelu :
Les routines capillaires inadaptées affectent directement l’équilibre microbien. Trop de lavages éliminent les micro-organismes protecteurs, tandis qu’un manque d’hygiène favorise la prolifération de de microorganismes métabolisant le sébum, induisant irritation et pellicules. (5).
L’impact des produits cosmétiques est également à prendre en compte. Les shampoings contenant des tensioactifs agressifs altèrent l’équilibre du microbiome du cuir chevelu et favorisent la colonisation par des levures pathogènes (3,6).
Le mode de vie influence également cet écosystème. Le stress chronique modifie la composition microbienne, tandis qu’une alimentation déséquilibrée peut favoriser les états inflammatoires (4).
Les facteurs environnementaux comme la pollution et l’humidité peuvent modifier la diversité microbienne du cuir chevelu, entraînant un terrain propice aux déséquilibres.(1,3)
Les dysbioses du cuir chevelu
Quand l’équilibre du microbiome du cuir chevelu est perturbé, plusieurs pathologies peuvent apparaître :
Pellicules : La prolifération excessive de Malassezia, associée à une surproduction de sébum, accélère la desquamation du cuir chevelu. Une étude a montré que Malassezia restricta et Malassezia globosa sont les espèces les plus associées aux états pelliculaires. (1)
Dermatite séborrhéique : Caractérisée par une inflammation et des squames grasses, cette pathologie est liée à une interaction entre Malassezia, le système immunitaire et la production lipidique. Des analyses métagénomiques ont révélé des déséquilibres dans les proportions relatives de Cutibacterium acnes et Malassezia chez les patients atteints de dermatite séborrhéique. (1)
Alopécie : Certaines études suggèrent qu’un déséquilibre du microbiome du cuir chevelu pourrait favoriser des conditions inflammatoires menant à une perte de cheveux. De plus une réduction de Cutibacterium acnes a été observée dans certains types d’alopécie. (4)
Restaurer un microbiome du cuir chevelu sain nécessite une approche globale :
Chez BYOME LABS, nous mesurons l’impact des produits capillaires sur le microbiome du cuir chevelu grâce à des tests in vitro innovants basés sur la culturomique. Notre expertise cumulée de 20 ans nous permet d’analyser précisément la diversité et l’équilibre microbien après application de vos formulations, sur des modèles mimant l’environnement du cuir chevelu (pH, addition de sébum, température, etc.). Nous étudions l’impact de vos produits cosmétiques ou pharmaceutiques sur le microbiome du cuir chevelu.
Nous testons vos produits sur des panels représentatifs incluant Cutibacterium acnes et les différentes espèces de Malassezia, particulièrement complexes à cultiver. Notre approche unique évalue l’impact sur les biofilms, forme naturelle d’organisation des micro-organismes sur le cuir chevelu.
Nos protocoles sur mesures permettent d’identifier les formulations qui préservent l’équilibre des micro-organismes commensaux tout en régulant les populations pathogènes. Les marques leaders du secteur capillaire nous font confiance pour valider leurs allégations « microbiome-friendly » et développer des soins respectueux du microbiome du cuir chevelu.
La compréhension du microbiome du cuir chevelu révolutionne le développement des produits capillaires. Les consommateurs exigent désormais des formulations qui respectent et protègent cet écosystème fragile.
Les innovations futures intégreront des combinaisons sophistiquées de prébiotiques, postbiotiques et actifs ciblés pour maintenir l’homéostasie du microbiome du cuir chevelu. Cette approche personnalisée représente le futur des soins capillaires efficaces et durables.
Validez l’impact de vos formulations capillaires sur le microbiome ! Contactez nos experts pour une évaluation personnalisée et différenciez vos produits sur le marché des soins capillaires respectueux du microbiome.
Notre site utilise des cookies pour améliorer votre expérience de navigation. En continuant à utiliser notre site, vous acceptez notre utilisation de cookies conformément à notre politique de confidentialité.